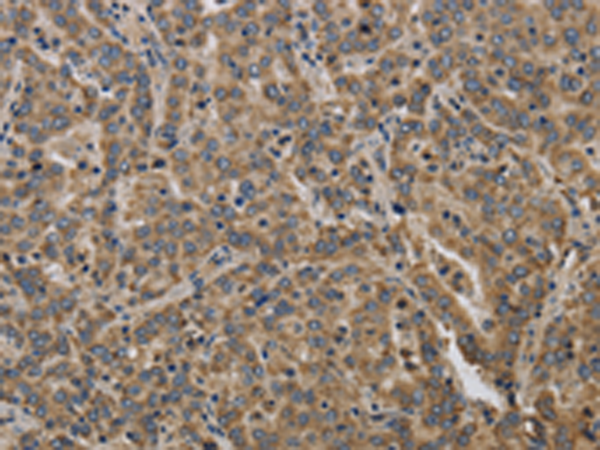
一抗

|
Background: |
MaxiK channels are large conductance, voltage and calcium-sensitive potassium channels which are fundamental to the control of smooth muscle tone and neuronal excitability. MaxiK channels can be formed by 2 subunits: the pore-forming alpha subunit and the modulatory beta subunit. The protein encoded by this gene is an auxiliary beta subunit which decreases the activation time of MaxiK alpha subunit currents. Alternative splicing results in multiple transcript variants of this gene. Additional variants are discussed in the literature, but their full length nature has not been described. |
|
Applications: |
ELISA, IHC |
|
Name of antibody: |
KCNMB2 |
|
Immunogen: |
Synthetic peptide of human KCNMB2 |
|
Full name: |
potassium large conductance calcium-activated channel, subfamily M, beta member 2 |
|
SwissProt: |
Q9Y691 |
|
ELISA Recommended dilution: |
2000-10000 |
|
IHC positive control: |
Human liver cancer and Human brain |
|
IHC Recommend dilution: |
50-200 |

 購物車
購物車 幫助
幫助
 021-54845833/15800441009
021-54845833/15800441009